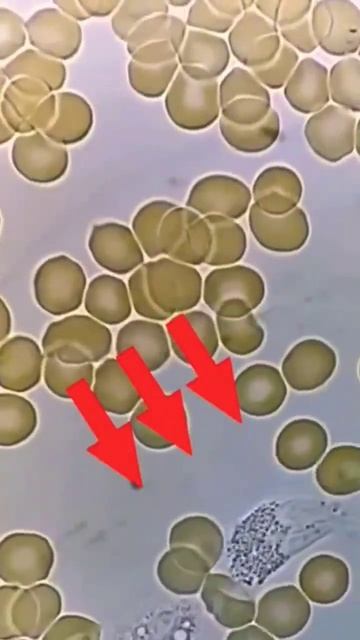
Exploring the Fascinating World of Blood Cells: A Microscopic Journey through the Human Body. #shor смотреть онлайн

Автор / Канал: College Genius Страница 9

забавные животные кот 360

I found the Nicolas cage gummy bear! (Roblox find the gummy bears)

Gauss 8 2012 12

Bad bunny ft. Drake-Mia (Dj sanjay moombahton mashup 2022)

27-11-2021 первая перегонка 12 литров 35 градусов, в два приема 7.5 часа

How to Control Servo motor by Potentiometer | Arduino | TinkerCad

R,S configuration of 2D/Fischer Projection molecules II #jeeadvanced2021

Prophet Richard Gray ~ Prophecy for South Africa(5 January 2020)

Картофельная пушка

kill background Sound

Anakin Skywalker - Redemption

Fit Rite Hydraulics John Deere 2520 & 2720 Hydraulic Top and Tilt Kit

Как моют блок двигателя "МехРемДвс"

Smudges Phenomenon warriors AMV

LeBwa CUP l Розыгрыш коробок

Cooking Battle | Anubis and Domp Tandem Serve It Hard Watch Out!

•~|Пико-Вару|~•

Vaidik lagna vidhi...bride entry by SINGER DEVI GALA CHHEDA
![#Ae-17 Cast Shadow and Material optians in after effects [in HINDI] смотреть онлайн #Ae-17 Cast Shadow and Material optians in after effects [in HINDI] смотреть онлайн](https://pic.rtbcdn.ru/video/2025-01-17/81/67/81672b7b2541c6023351e1772f497fac.jpg)
#Ae-17 Cast Shadow and Material optians in after effects [in HINDI]

How I used my struggles to build a successful business (Sparkle My Yard)

Find the equivalent weight of NaCl | neet chemistry

Una Adventura (2)

Leriko RUSSIAN MAGIC PARTY
Exploring the Fascinating World of Blood Cells: A Microscopic Journey through the Human Body. #shor
За каждым успешным каналом стоит личность, идея и сотни часов кропотливого труда. Если вы здесь, значит, автор «College Genius» уже сумел зацепить ваше внимание своим уникальным стилем или подачей. А мы на RUVIDEO позаботились о том, чтобы вы могли изучить весь архив его работ в максимально комфортных условиях — без лишней суеты и преград.
Почему за работами канала «College Genius» так интересно наблюдать? Всё просто: это честный контент, который находит отклик в сердцах зрителей. На нашем ресурсе вы можете смотреть онлайн все видео любимого автора бесплатно и в хорошем качестве. Нам важно, чтобы вы видели каждую деталь и слышали каждый нюанс, поэтому мы используем только стабильные плееры из открытых источников Rutube.
Следите за новинками канала, пересматривайте старые шедевры и открывайте для себя новые грани творчества «College Genius». Мы постоянно обновляем ленту, чтобы у вас под рукой всегда были самые свежие выпуски. Никаких сложных регистраций — только вы и творчество, которое вдохновляет. Приятного вам путешествия по миру авторского контента на RUVIDEO!
Видео взято из открытых источников Rutube. Если вы правообладатель, обратитесь к первоисточнику.